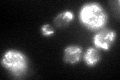
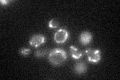

View description
Mitochondrial ribosomal protein of the small subunit, has similarity to mammalian apoptosis mediator proteins; null mutation prevents induction of apoptosis by overproduction of metacaspase Mca1p
Localization:
Intensity:
Fold change:
Significance:
-
C’ GFP library in SD

mitochondria46.18 -
N' NOP1pr-GFP in SD

mitochondria81.0159 -
N' TEF2pr-mCherry in SD

mitochondria77.8254 -
N' NATIVEpr-GFP in SD

missing0 -
N' TEF2pr-VC and Cyto-VN in SD

#N/A0 -
C’ GFP library in SD+DTT
mitochondria48.121.04No -
C’ GFP library in SD+H2O2

mitochondria34.390.74No -
C’ GFP library in Starvation Media
mitochondria52.611.13No -
C’ GFP library on the background of Pup2-DaMP

mitochondria -
C’ GFP library on the background of CCT mutant

mitochondria32.54280.704574No
